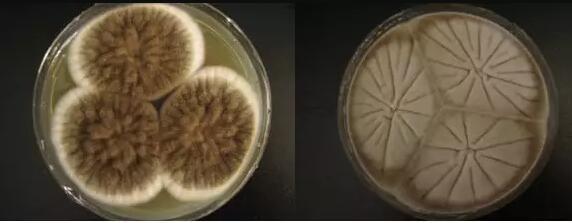

海博微信公众号
海博微信公众号
 海博天猫旗舰店
海博天猫旗舰店


 海博微信公众号
海博微信公众号
 海博天猫旗舰店
海博天猫旗舰店




将微生物接到适于它生长繁殖的人工培养基上或活的生物体内的过程叫做接种。
接种和分离工具
1.接种针 2.接种环 3.接种钩 4.5.玻璃涂棒 6.接种圈 7.接种锄 8.小解剖刀
常用的接种方法有以下几种:
1、划线接种
这是最常用的接种方法。即在固体培养基表面作来回直线形的移动,就可达到接种的作用。常用的接种工具有接种环,接种针等。在斜面接种和平板划线中就常用此法。

2、三点接种
在研究霉菌形态时常用此法。此法即把少量的微生物接种在平板表面上,成等边三角形的三点,让它各自独立形成菌落后,来观察、研究它们的形态。除三点外,也有一点或多点进行接种的。
3、穿刺接种
在保藏厌氧菌种或研究微生物的动力时常采用此法。做穿刺接种时,用的接种工具是接种针。用的培养基一般是半固体培养基。它的做法是:用接种针蘸取少量的菌种,沿半固体培养基中心向管底作直线穿刺,如某细菌具有鞭毛而能运动,则在穿刺线周围能够生长。

4、浇混接种
该法是将待接的微生物先放入培养皿中,然后再倒入冷却至45°c左右的固体培养基,迅速轻轻摇匀,这样菌液就达到稀释的目的。待平板凝固之后,置合适温度下培养,就可长出单个的微生物菌落。
5、涂布接种
与浇混接种略有不同,就是先倒好平板,让其凝固,然后再将菌液倒入平板上面,迅速用涂布棒在表面作来回左右的涂布,让菌液均匀分布,就可长出单个的微生物的菌落。
6、液体接种
从固体培养基中将菌洗下,倒入液体培养基中,或者从液体培养物中,用移液管将菌液接至液体培养基中,或从液体培养物中将菌液移至固体培养基中,都可称为液体接种。

7、注射接种
该法是用注射的方法将待接的微生物转接至活的生物体内,如人或其它动物中,常见的疫苗预防接种,就是用注射接种,接入人体,来预防某些疾病。
8、活体接种
活体接种是专门用于培养病毒或其它病原微生物的一种方法,因为病毒必须接种于活的生物体内才能生长繁殖。所用的活体可以是整个动物;也可以是某个离体活组织,例如猴肾等;也可以是发育的鸡胚。接种的方式是注射,也可以是拌料喂养。
注:有所接种必须无菌操作
培养基经高压灭菌后,用经过灭菌的工具(如接种针和吸管等)在无菌条件下接种含菌材料(如样品、菌苔或菌悬液等)于培养基上,这个过程叫做无菌接种操作。在实验室检验中的各种接种必须是无菌操作。
上一篇:几种常用的灭菌方法汇总
下一篇:微生物菌种保存方法汇总



